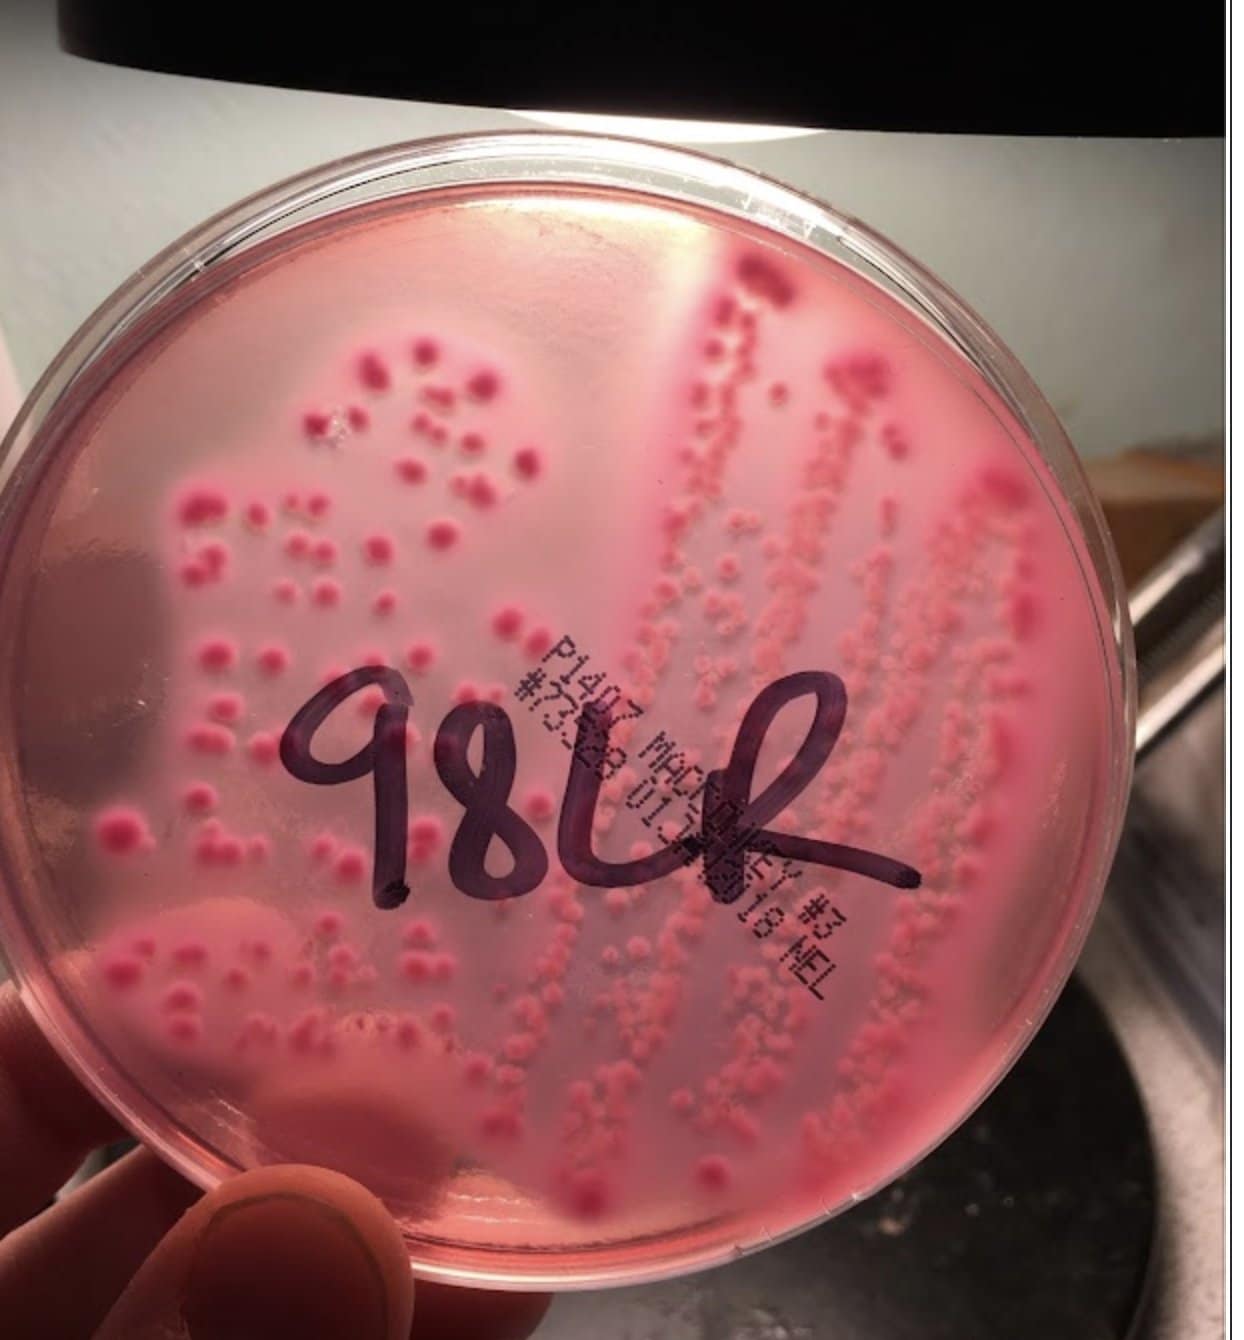
MacConkey20plate20growth 88

Tuesday, December 2
Question of the Day
A milk sample is sent into the clinic for culture from a third lactation Jersey cow with a history of decreased appetite, drop in milk production, and temperature of 103.5ºF (39.7ºC) [Normal = 100.4-102.8ºF (38.0–39.3ºC)].
There is growth on both the blood agar and Macconkey culture plates. Growth on the Macconkey looks like the image below.
What is the best treatment recommendation for this cow?
